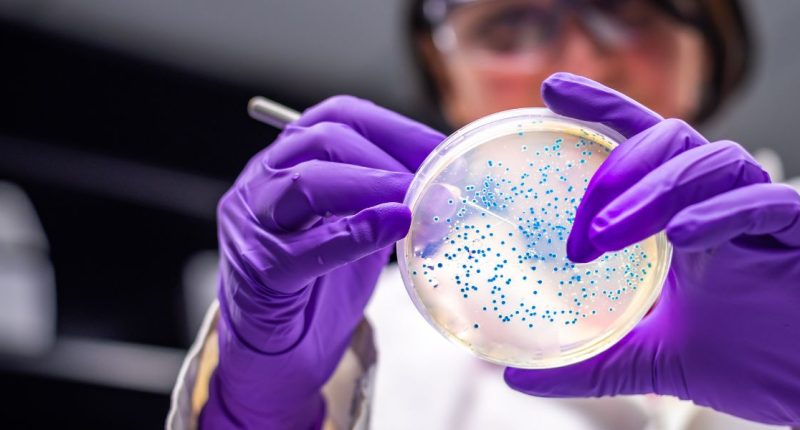

A pioneering immunotherapy drug to treat type 1 diabetes is soon to be tested on human participants for the first time.
Scientists from the University of Queensland want to recruit five people with type 1 diabetes to receive the targeted immunotherapy drug ‘ASITI-201’.
Designed to rebalance the body’s immune response, the ASITI-201 drug can protect insulin-producing pancreatic cells.
- Study to determine if type 1 diabetes can be treated with osteoporosis medication
- Automated insulin delivery systems beneficial for older adults with type 1 diabetes
- Religious sect’s leader and parents jailed for death of 8-year old with type 1 diabetes
Lead author Professor Ranjeny Thomas said: “In people with type 1 diabetes, the immune system starts to recognise pancreatic cells as something it needs to attack, and right now the only available treatment is insulin replacement.
“We’ve taken a new approach and developed ASITI-201 using a protein from the pancreas, along with vitamin D to calm the immune response. This potential treatment uses the immune system’s ability to heal.”
Co-author Dr Aakansha Zala said: “The drug candidate aims to preserve as much pancreatic function for as long as possible in people recently diagnosed with type 1 diabetes, to reduce the amount of insulin they need to administer.
“We are looking for people over the age of 18 who have been diagnosed with type 1 diabetes within the last five years, to participate in the trial at the Translational Research Institute’s Clinical Research Facility based at Brisbane’s Princess Alexandra Hospital.”
Dr Zala added: “We will be looking at whether the drug changes the immune systems in the way that we anticipate.”
Affecting roughly 120,000 people in Australia, type 1 diabetes is often diagnosed during childhood or young adulthood.
- Islet transplantation with blood vessel cells shows promise for treating type 1 diabetes
- Kidney disease among people with type 1 diabetes triggered by yo-yo dieting
- Type 1 diabetes-related problems predicted by continuous glucose monitors
Professor Thomas stated: “Ultimately, we need to move to larger trials which include children, who have a much faster progression to insulin dependence.
“We’ve been developing a similar drug with the potential to treat rheumatoid arthritis, and that knowledge has supported our development of this drug for type 1 diabetes.”
Programme Officer at the Helmsley Charitable Trust, Dr Ben Williams concluded: “The organisation is proud to have supported the research which is a step towards improving the lives of people with type 1 diabetes. Bringing drug candidates from the laboratory into clinical testing is always a herculean effort.”